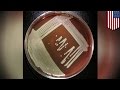

| |
|
 | | time | views | |
 | Church shooting: Man shot dead by fellow churchgoer at Montgomeryville service - TomoNews | 1:60 | 0 | |
 | Terrorist blows himself up along with nine other militants assembling IEDs at mosque - TomoNews | 0:52 | 0 | |
 | Ohio execution-style murders: 8 members of same family killed in their homes - TomoNews | 1:13 | 0 | |
 | Prom shooting: teen gunman killed by police after opening fire outside school dance - TomoNews | 1:35 | 0 | |
 | Chinese hacker SexyCyborg’s hacking gadget, 3D-printed Cortex Exoskeleton - 3D printing compilation | 15:26 | 0 | |
 | Fake emergency doors, fake condoms, fake cops, fake doctors and fake phones - Fake stuff compilation | 17:30 | 0 | |
 | Woman drives to her death into high water, Teacher chokeslams 14-yr-old student - 04/22/2016 | 21:40 | 0 | 1 list |
 | Circumcised and uncircumcised men enjoy the same amount of sensitivity, study shows - TomoNews | 1:11 | 0 | |
 | Saudi 9/11 connection? New evidence suggests Saudi government link to terror attacks - TomoNews | 2:35 | 0 | |
 | Bacteria-powered solar panel can create clean and sustainable energy - TomoNews | 1:24 | 0 | |
 | Body cam footage released of moment felon shot and killed Oregon cop - TomoNews | 1:34 | 0 | |
 | Caught on camera: Guy on drugs harasses drivers, jumps in front of moving car - TomoNews | 1:51 | 0 | |
 | Whirlwind lifts Chinese school kid into the air: Dust devils at sports day cause terror - TomoNews | 0:47 | 0 | 1 list |
 | Student fights teacher: Milwaukee teaching aide chokeslams boy to ground in classroom - TomoNews | 1:10 | 0 | |
 | RIP Prince: Iconic legendary musician, singer dead at the age of 57 - TomoNews | 1:19 | 0 | 1 list |
 | Fatal high school fight: Delaware teenager killed in bathroom fight over a boy - TomoNews | 1:10 | 0 | |
 | STD super gonorrhea! Antibiotic-resistant strain spreading throughout the UK- TomoNews | 1:17 | 0 | |
 | NASA rocket explodes 6 seconds after takeoff; Virgin Galactic crash - space fails compilation | 21:38 | 0 | 1 list |
 | Snake bites man trying to kiss it; boy bitten by world's most venomous land snake - compilation | 14:20 | 0 | |
 | Female cop suspended after topless photo gone viral, VR porn coming to Vegas hotel room - 04/21/2016 | 15:90 | 0 | 1 list |
 | Petrochemical plant explosion: Massive blast at Mexico's Pemex facility kills 24 - TomoNews | 1:50 | 0 | |
 | Killer waves send world's 'most beautiful' bike path crashing into the sea, killing two - TomoNews | 1:10 | 0 | |
 | World's largest hornet which can dissolve human tissue with its venom terrifies woman - TomoNews | 1:27 | 0 | |
 | Vibrating pleasure tool: Lioness lady 'smart' massager is a fitbit for your pink bits - TomoNews | 1:19 | 0 | |
 | Surveillance video shows chilling moment woman drowns in her car during Houston flood - TomoNews | 1:90 | 0 | |
 | Electrocution death: Ohio boy dies trying to recreate Jacob's Ladder YouTube experiment - TomoNews | 1:10 | 0 | |
 | Brothers wanted for murder: Police looking for two brothers in murder of missing couple - TomoNews | 1:80 | 0 | |
 | UFO sighted at International Space Station just before NASA feed cuts out - TomoNews | 1:14 | 0 | 1 list |
 | Tons of drugs seized from longest drug tunnel ever found under U.S.-Mexico border - TomoNews | 1:18 | 0 | |
 | Lip surgery: Selfie takers seeking perfect pout behind huge rise in U.S. lip surgery - TomoNews | 1:16 | 0 | |
 | Harriet Tubman $20: Civil rights hero bumps President Andrew Jackson from U.S. $20 bill - TomoNews | 1:45 | 0 | |
 | Chinese government silences popular Internet sensation Papi Jiang and orders reform - TomoNews | 1:50 | 0 | 1 list |
 | School fight: Elementary kids in Tennessee handcuffed for failing to break up fight - TomoNews | 1:35 | 0 | |
 | Dog rescue compilation: amazing dog rescue; police save dog; dog in hot car; drowning dog & more | 25:48 | 0 | |
 | Drunk monkey terrorizes neighborhood; firecracker prank claims macaque's finger - monkey compilation | 16:56 | 0 | |
 | Public sex during Cleveland Indians game, street performer kicks man in the face - 04/20/2016 | 16:30 | 0 | 1 list |
 | Eating dog meat: Millionaire spends fortune on home for dogs destined for slaughter - TomoNews | 1:34 | 0 | is in 2 lists |
 | Voluptuous Mexican cop Nidia Garcia suspended after racy Facebook pic goes viral - TomoNews | 1:32 | 0 | |
 | One-punch death: Harrow School pupil killed by single punch from Malia club promoter - TomoNews | 1:31 | 0 | |
 | Virtual reality porn: Las Vegas hotels put VR erotica headsets in guest rooms - TomoNews | 1:29 | 0 | |
 | US primary elections: Trump and Clinton score big wins in New York primaries - TomoNews | 1:33 | 0 | 1 list |
 | Pope vs Trump over US-Mexico border issues, Pope releases rock album - Pope Francis compilation | 19:49 | 0 | |
 | Space balloon to lift tourists into space, Virgin Galactic SpaceshipTwo - space tourism compilation | 17:34 | 0 | |
 | American tourist going down on Thai girl in public, ‘Robot Goddess’ unveiled in China - 04/19/2016 | 13:31 | 0 | 1 list |
 | Public sex at MLB New York Mets vs. Cleveland Indians game at Progressive Field - TomoNews | 1:10 | 0 | |
 | Cat ransom: College student arrested for demanding $20 ransom for lost kitten - TomoNews | 1:24 | 0 | 1 list |
 | From fish to man: New study finds human limbs may have evolved from fish gills - TomoNews | 1:33 | 0 | |
 | Full face transplant: Mitch Hunter lost face in crash that zapped him with 10,000 volts - TomoNews | 1:55 | 0 | |
 | Bristol residents protest conversion of porn studio into housing for migrant workers - TomoNews | 1:24 | 0 | |
 | Self-defense: Times Square street performer kicks guy in the face for robbery attempt - TomoNews | 0:45 | 0 | |
 | Man drowns while rescuing daughter, hours before his own father's funeral in Florida - TomoNews | 0:54 | 0 | |
 | Muslim kicked off plane: Arabic-speaking student removed from Southwest Airlines flight - TomoNews | 1:28 | 0 | |
 | Caught cheating at home: Smart mattress 'Smarttress' can tell if you're being played - TomoNews | 1:60 | 0 | |
 | 'FBI' stripper with 'assault rifle' freaks out Frankfurt red light district - TomoNews | 0:55 | 0 | |
 | Suspect wearing police SWAT gear wanted for murder in church of Texas fitness instructor-TomoNews | 1:18 | 0 | |
 | 'Trillions' of cicada set to swarm northeastern US after 17 years underground - TomoNews | 1:26 | 0 | 1 list |
 | Archeology discovery: Ancient Roman villa discovered under Wiltshire, England farmhouse - TomoNews | 1:32 | 0 | |
 | Wearable electronics: E-skin turns your body into an LED display - TomoNews | 1:30 | 0 | |
 | NASA's laser-powered spacecraft will fly to Mars in 72 hours - Mars exploration compilation | 19:32 | 0 | is in 2 lists |
 | Sexiest Instagram compilation: What the Rich Kids of Instagram did on vacation, Women of Instagram | 21:00 | 0 | |
 | Public sex assault: American charged with indecency after oral sex on Thai woman - TomoNews | 1:23 | 0 | |
 | Gator eats gator caught on tape, photog jailed for taking nude photoshoots in Tibet - 04/18/2016 | 10:50 | 0 | 1 list |
 | 4.5 GPA but begging for college tution: High schooler forced panhandle outside Target - TomoNews | 1:27 | 0 | |
 | 'Robot goddess' unveiled at Chinese university, hot robot modeled after 5 hottest girls - TomoNews | 1:28 | 0 | 1 list |
 | Shark attack: pregnant Ragged Tooth shark attacks diver caught on video - TomoNews | 2:44 | 0 | is in 2 lists |
 | Purrrfect catch: Cute cats go on fishing trip with a man - TomoNews | 0:52 | 0 | 1 list |
 | Baby left in hot car: Woman accused of leaving daughter in car for strip club audition - TomoNews | 1:80 | 0 | |
 | Rangers FC promotion: Glasgow side rejoin Premiership and beat rivals Celtic for 1st time in years | 1:38 | 0 | 1 list |
 | Ring of Fire: Earthquakes and volcanic eruptions around the Pacific explained - TomoNews | 1:43 | 0 | |
 | Islamophobia in America: Muslim kicked off Southwest Airlines plane for changing seats - TomoNews | 1:17 | 0 | |
 | Explosion at cockroach-infested apartment: Pests unfazed by fumigation explosion - TomoNews | 0:59 | 0 | |
 | Drone hits British Airways plane in London's Heathrow airport - TomoNews | 2:80 | 0 | 1 list |
 | Nude Chinese model photoshoot at Tibetan lake gets photographer 10 days in jail - TomoNews | 1:30 | 0 | 1 list |
 | Russian jets buzz U.S. destroyer, naked woman high on spice, sax causes car accident - 04/15/2016 | 20:58 | 0 | 1 list |
 | Accidentally shot: Real gun goes off at Texas in water gun fight, teen hospitalized - TomoNews | 1:40 | 0 | 1 list |
 | Gator eats gator video: alpha-gator devouring beta-gator offers important life lessons - TomoNews | 1:40 | 0 | 1 list |
 | NASA saves planet-hunting Kepler space telescope after it enters emergency mode - TomoNews | 1:16 | 0 | 1 list |
 | Global warming: Melting of Greenland and Antarctica is moving the North and South poles - TomoNews | 1:45 | 0 | |
 | Solar Impulse to set to resume round-the-world journey in late April - TomoNews | 2:17 | 0 | |
 | Sexiest car accident: man crashes car while having sex, blames unseen gunman - TomoNews | 1:18 | 0 | |
 | Ted Cruz 'has jerked off to porn a million times,' says his Princeton college roommate - TomoNews | 1:59 | 0 | 1 list |
 | Tinder horror story: Woman refuses sex on first date with loser man, he demands $90 - TomoNews | 1:80 | 0 | |
 | Bees attack man: Arizona man stung thousands of times and revived after deadly bee attack - TomoNews | 1:16 | 0 | |
 | Real-life Ken doll rushed to hospital with infection after nose job gone wrong - TomoNews | 2:10 | 0 | |
| Elizabethkingia infections: mysterious bacteria claims 20 lives in three states in the US - TomoNews | 1:90 | 0 | |
 | Dyson Airblade hand dryer spreads more germs than paper towels, study shows - TomoNews | 1:15 | 0 | |
 | Vape explodes and blinds 14-year-old kid in NYC mall, blast caused by battery explosion - TomoNews | 1:43 | 0 | |
 | Democratic debate 2016: Gloves off as Clinton, Sanders scrap in New York primary debate - TomoNews | 1:31 | 0 | 1 list |
 | North Korea missile fail: Musudan missile launch fails on Kim Il Sung's birthday - TomoNews | 1:26 | 0 | 1 list |
 | Dental disaster? Michigan woman dies after getting 16 teeth pulled at the dentist - TomoNews | 1:19 | 0 | |
 | Dirty old people: Cougar busted for romp with boy toy at retirement home - gerontophilia compilation | 19:53 | 0 | |
 | Half ton killer transformed after losing 600 pounds, world's fattest man slims down - compilation | 16:54 | 0 | |
 | Man masturbates on bus for three hours; cute wallaby in Australia; Warriors’ 73rd win - 04/14/2016 | 13:21 | 0 | 1 list |
 | Death by bullying: California sixth grader dies after being stomped on chest by bully - TomoNews | 1:70 | 0 | |
 | Rescue stories: Lost grandma eats plants to survive 9 days in Arizona wilderness - TomoNews | 1:16 | 0 | |
 | Whip spider: German man posts video of him getting attacked by whip spider - TomoNews | 0:53 | 0 | 1 list |
 | Dog stuck in a tree: Great Dane rescued from tree by Nebraska firefighters - TomoNews | 1:40 | 0 | |
 | Medical breakthrough: Brain chip allows paralyzed man to regain hand movement - TomoNews | 1:10 | 0 | |
 | Caught on camera: Woman high on Spice stripes naked and masturbates in front of crowd | 0:57 | 0 | |
 | Russia vs USA 2016: Two Russian fighter jets play chicken with U.S. warship in Baltic Sea - TomoNews | 1:18 | 0 | |
|
|
|